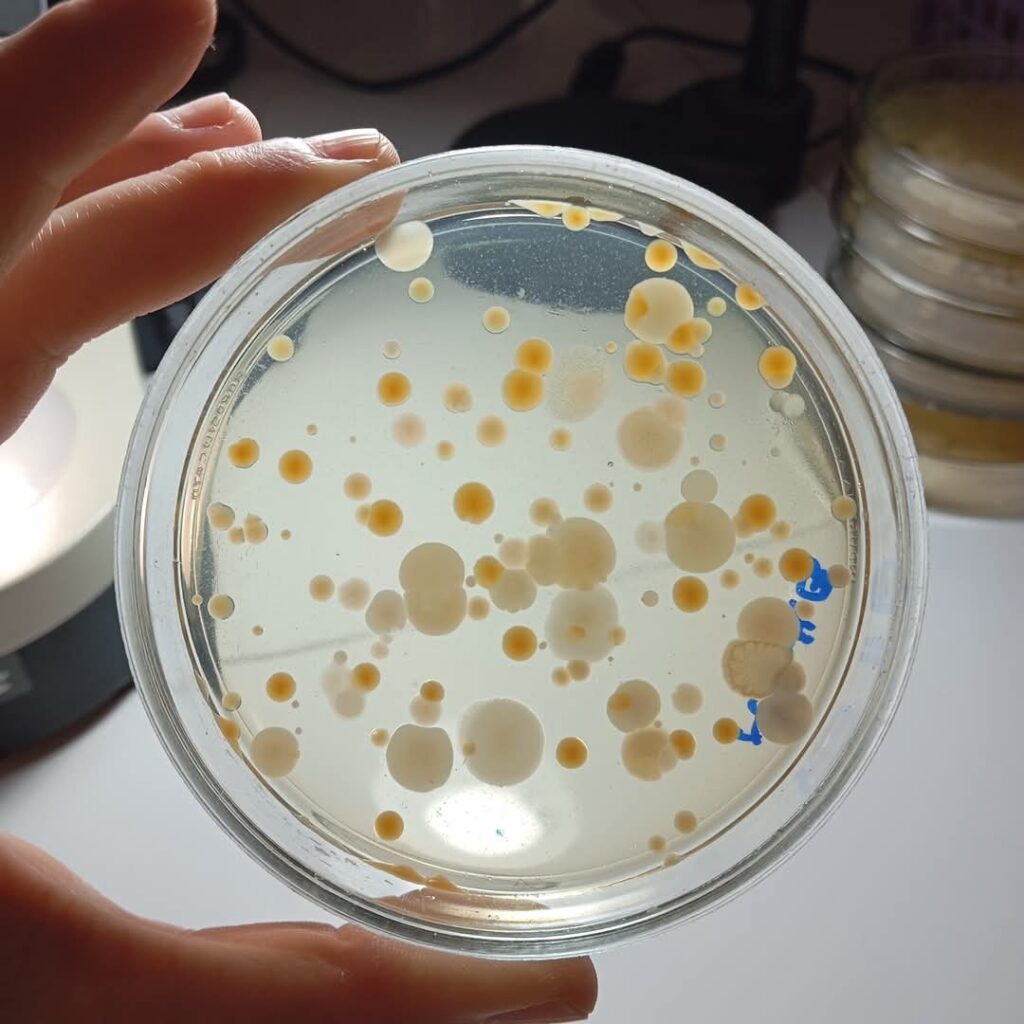

Famaillá Noticias
El rol clave de la microbiología del suelo en la producción sostenible de caña de azúcar

Investigadores del INTA Famaillá destacan la importancia de la microbiología del suelo para mejorar la productividad y sostenibilidad del cultivo de caña de azúcar en Tucumán. Ensayos con nuevas técnicas de labranza y cosecha buscan optimizar el rendimiento y reducir el impacto ambiental.
La microbiología del suelo es un factor determinante para lograr una producción más eficiente y sostenible de caña de azúcar en Tucumán. Así lo destacó la Dra. Paola Delaporte Quintana, investigadora del INTA Famaillá, quien subrayó la importancia de los microorganismos en procesos esenciales como el ciclo de nutrientes, la estructuración del suelo, el control de plagas y enfermedades, la estimulación del crecimiento vegetal y la biorremediación de suelos contaminados.
Un desafío para el sector cañero tucumano
En Tucumán, la producción de caña de azúcar ha alcanzado un límite productivo debido a la aplicación de técnicas agronómicas tradicionales que no consideran la microbiología del suelo. Para abordar este problema, la Estación Experimental Agropecuaria Famaillá, en conjunto con el INTA Castelar, está desarrollando un innovador ensayo comparativo entre dos sistemas de manejo agronómico:
Labranza convencional y cosecha integral: esta práctica genera una alta perturbación del suelo y aumenta su compactación.
Labranza reducida en franjas y cosecha liviana con la “Cañera INTA”: este método disminuye la alteración del suelo y reduce la compactación.
Resultados prometedores
Estudios previos indican que la labranza reducida en franjas permite reducir el tiempo operativo a la mitad y disminuir el consumo de combustible en un 60%. Además, al combinarse con una cosecha liviana, se logra mejorar la estructura del suelo con el tiempo.
Durante el primer año de ensayo, los investigadores observaron un aumento en la actividad microbiológica del suelo en las parcelas donde se aplicó la labranza reducida y la cosecha liviana, lo que se tradujo en un incremento cercano al 10% en el rendimiento del cultivo.
Formación y futuro del sector
El INTA Famaillá, en colaboración con la Universidad Nacional de Tucumán, está trabajando en la formación de nuevos profesionales especializados en esta área. A través de convenios con la Facultad de Agronomía, Zootecnia y Veterinaria, se busca fortalecer la capacitación en microbiología del suelo y manejo agronómico sostenible, garantizando el desarrollo de investigaciones que permitan superar el techo productivo actual y mejorar la sostenibilidad del sector cañero en la región.



